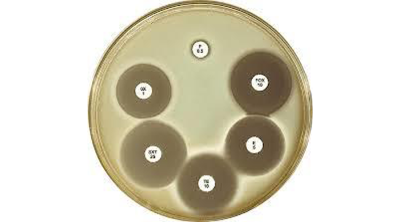
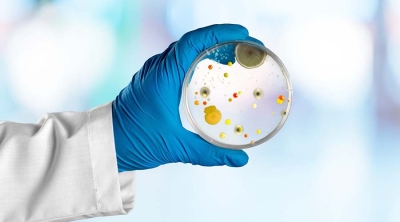

Our Blog

Botanical Identification Testing: Techniques, Methods & Importance.
Read More →
Enzyme Activity Assay: What Actually Matters in Real Lab Conditions
Read More →%20Testing%20Importance,%20Applications,%20and%20Role%20in%20Ensuring%20Water%20Quality.webp)
Total Organic Carbon (TOC) Testing: Importance, Applications, and Role in Ensuring Water Quality
Read More →
Choosing the Right Bacterial Endotoxin Testing Method for Accurate Results
Read More →
Ensuring Excellence, Detecting Impurities Through Raw Materials Testing First
Read More →
Amazon’s Certification Requirements for Dietary Supplement Products
Read More →
Understanding Nitrosamine Impurities: What You Need to Know
Read More →
Services for Bacterial Endotoxin Testing
Read More →
Services for Antimicrobial effectiveness testing
Read More →
Services for Enumeration of Probiotics
Read More →
Services of Antibiotic Potency Assays at Chromak Research
Read More →
Exploring the Science Behind Botanical ID Testing
Read More →
Exploring Extractables and Leachables Analysis
Read More →.jpg)
The Importance of Container Closure Integrity Testing (CCIT)
Read More →
Services of Sterility testing at Chromak Research
Read More →
Antibiotic Potency Assays in Microbiology
Read More →